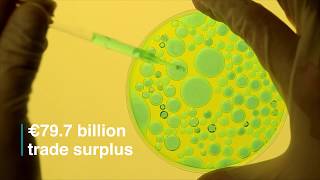

European Excellence: Making the EU a world leader in medical R&D video
Online izle ve mp4 mp3 formatlarinda yukle
Videonun muddeti: 0:57
European Excellence: Making the EU a world leader in medical R&D videosu mp4 ve mp3 yuklemek ucun hazirdir
Diqqet! Siz Mp4 yukle ve ya Mp3 yukle duymesine basdiqdan sonra eger sistem sizi reklam sehifesine atarsa o zaman derhal geri qayidib emeliyyati tekrar edin ve faylin yuklemek ucun hazir olmasini gozleyin
Videodan Mp4 Yukle
Videodan Mp3 Yukle-1
Videodan Mp3 Yukle-2
Oxshar Axtarishlar
European Excellence: Making the EU a world leader in medical R&D
PD 02 - Europe: Follower or Leader in Health Research and Innovation?
#LeaveALegacy - making Europe a world leader in global health research in 2018
#RiDaysEU | Research infrastructures β hubs of excellence, knowledge creation and innovation
Making Europe a world leader in supercomputing
Zelenskiy Thanks Leaders for Ukraine Support at EU Summit
What If European continent United ??? πͺπΊπΆ
Join us at the Global Europe Forum!
EU chief warns Trump over tariffs. #DonaldTrump #Tariffs #BBCNews
Video Mp4 Mp3Azwap.Biz
Azwap.Biz 2021-2023